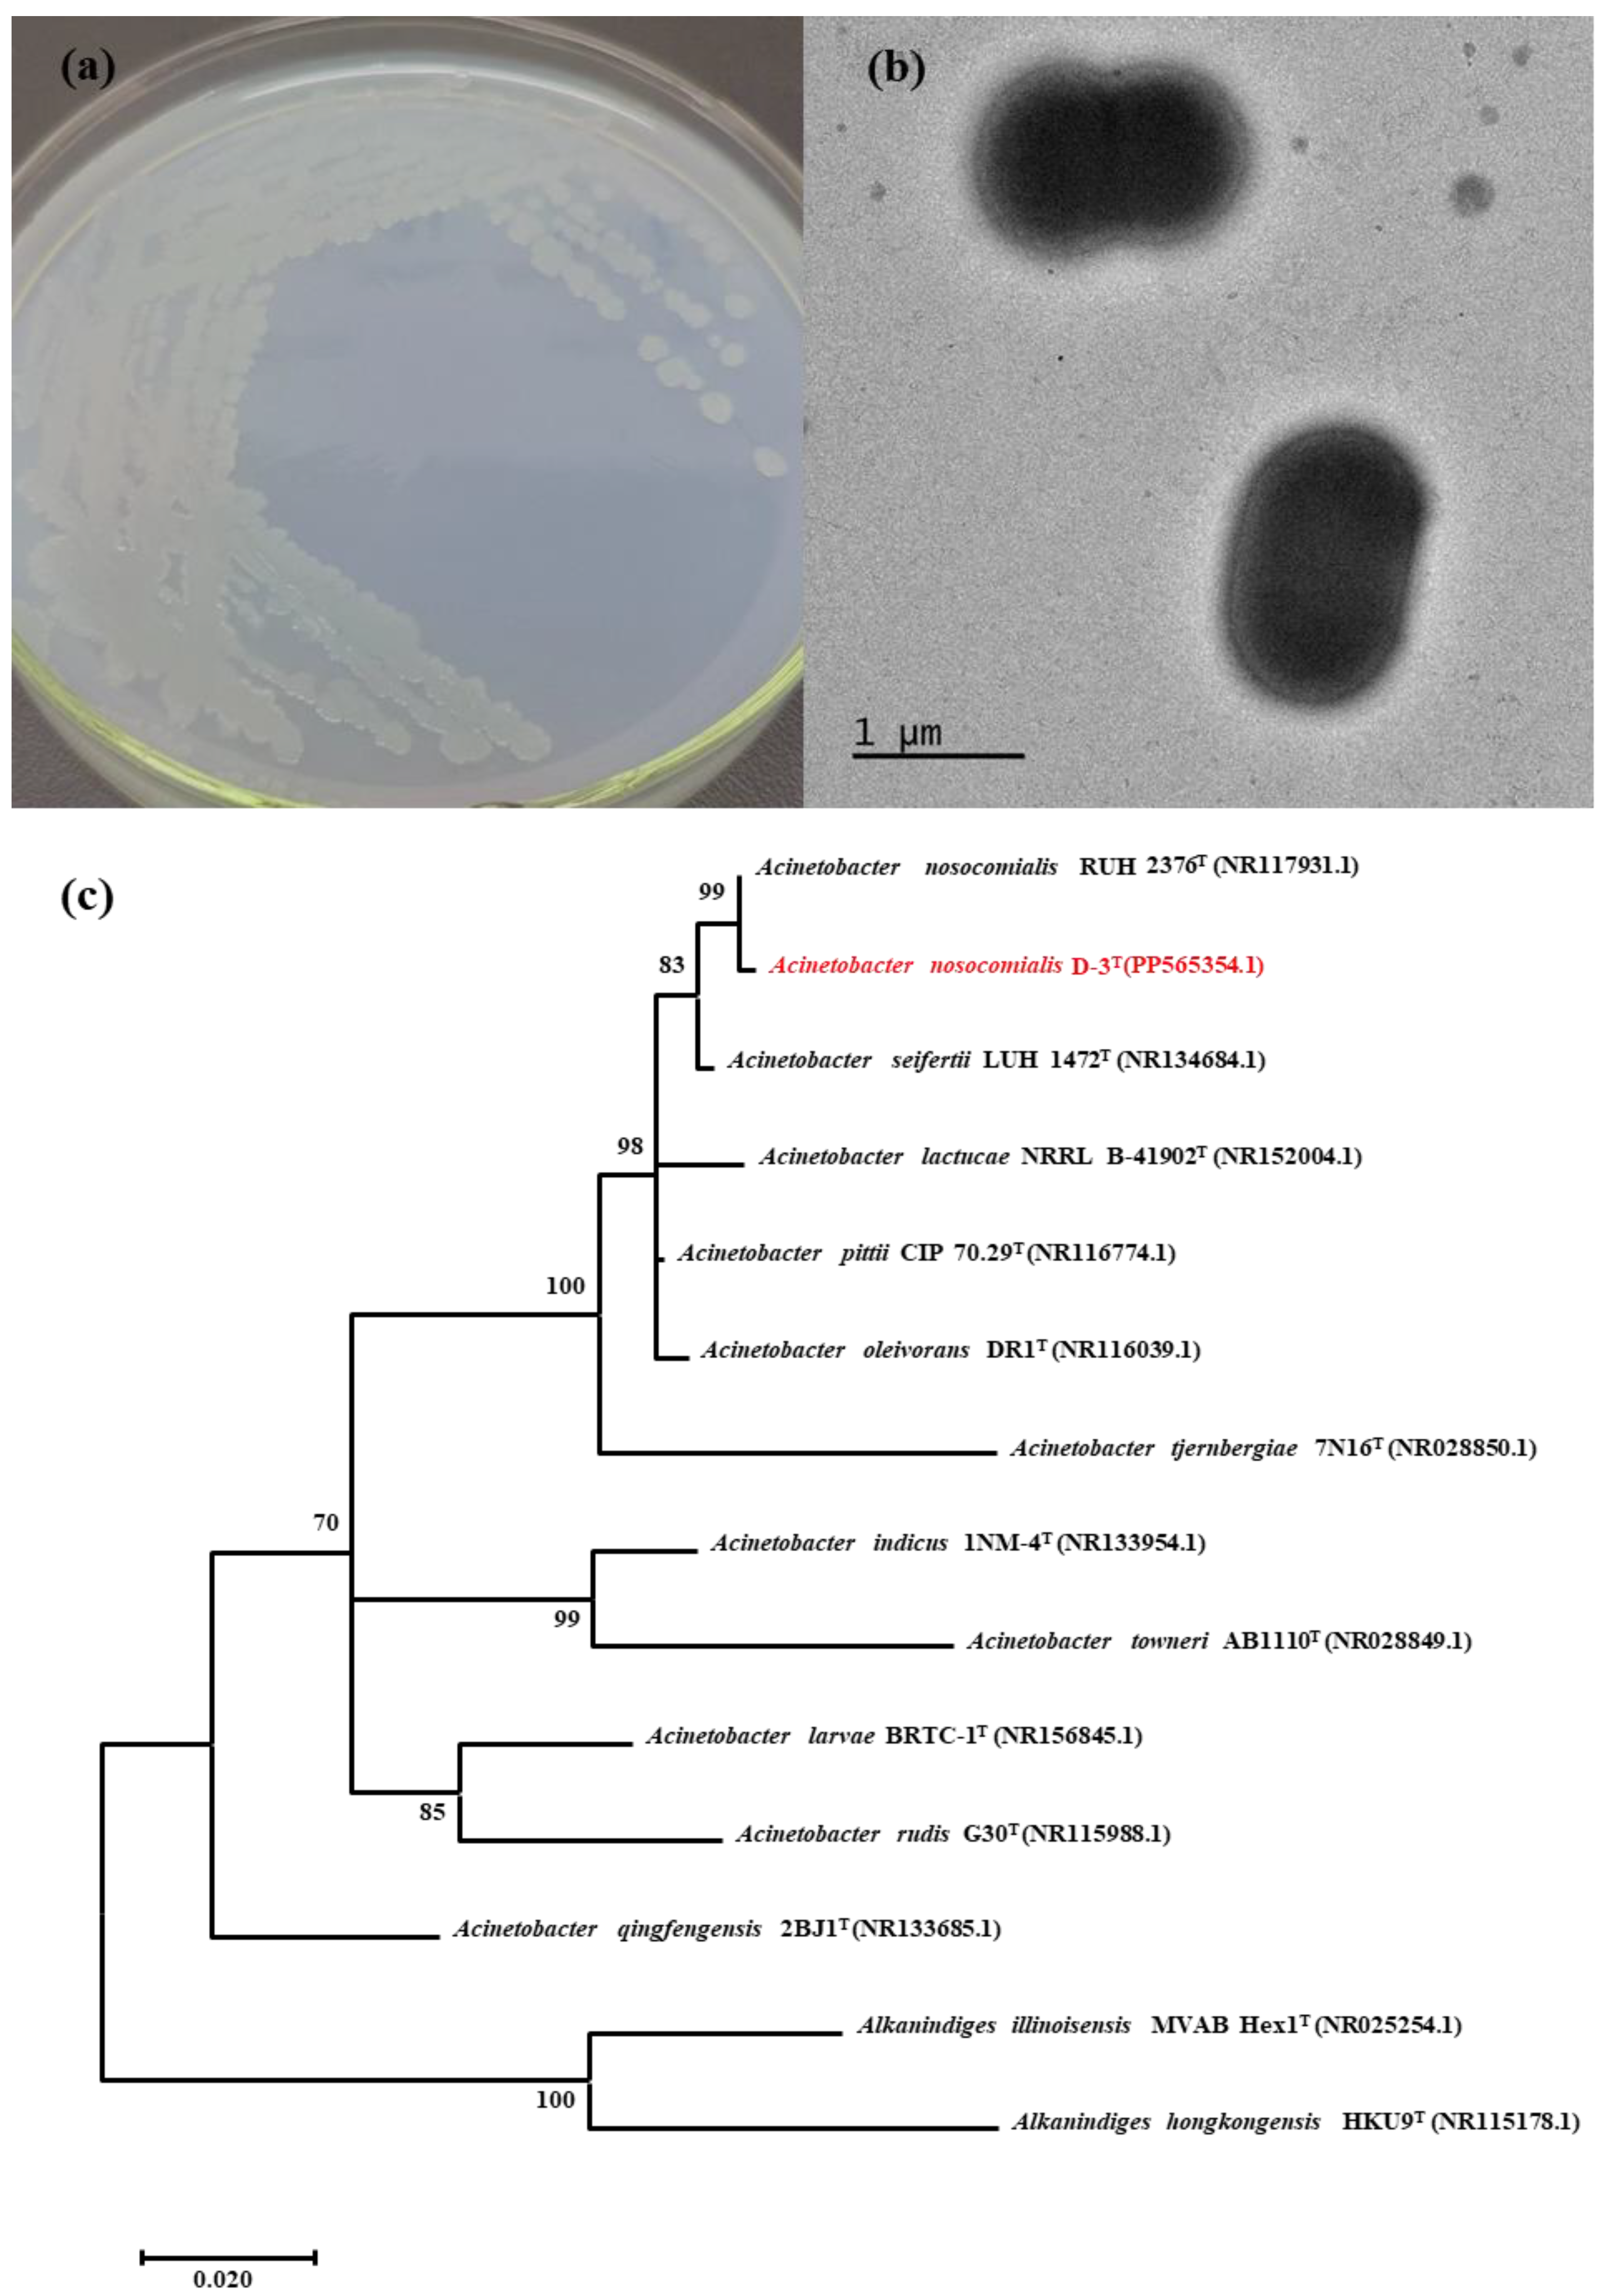
Molecules 29 02667 g003

Monitoring Ammonium Polyphosphate (APP) Biodegradation by Acinetobacter nosocomialis D-3 Using DAPI
Abstract
:1. Introduction
2. Results and Discussion
2.1. Analysis of APP Concentration by DAPI
2.2. Analysis of APP in JLS-PNA220-A by DAPI
2.3. Isolation and Identification of the APP-Degradation Strain
2.4. Effect of the Phosphorus Resource
2.5. Effect of Culture Temperature on the Degrading Ability of Acinetobacter nosocomialis D-3
2.6. Effect of Initial pH Values on the Degrading Ability of Acinetobacter nosocomialis D-3
3. Materials and Methods
3.1. Chemicals
3.2. Apparatus
3.3. Analysis of APP
3.4. JLS-PNA220-A Detection
3.5. Isolation, Enrichment, and Identification of Acinetobacter nosocomialis D-3
3.6. APP Degradation Conditions
4. Conclusions
Supplementary Materials
Author Contributions
Funding
Institutional Review Board Statement
Informed Consent Statement
Data Availability Statement
Acknowledgments
Conflicts of Interest
References
- Shen, J.; Liang, J.; Lin, X.; Lin, H.; Yu, J.; Wang, S. The Flame-Retardant Mechanisms and Preparation of Polymer Composites and Their Potential Application in Construction Engineering. Polymers 2021, 14, 82. [Google Scholar] [CrossRef] [PubMed]
- Sharkey, M.; Harrad, S.; Abou-Elwafa Abdallah, M.; Drage, D.S.; Berresheim, H. Phasing-out of legacy brominated flame retardants: The UNEP Stockholm Convention and other legislative action worldwide. Environ. Int. 2020, 144, 106041. [Google Scholar] [CrossRef] [PubMed]
- Davidson, D.J.; McKay, A.P.; Cordes, D.B.; Woollins, J.D.; Westwood, N.J. The Covalent Linking of Organophosphorus Heterocycles to Date Palm Wood-Derived Lignin: Hunting for New Materials with Flame-Retardant Potential. Molecules 2023, 28, 7885. [Google Scholar] [CrossRef] [PubMed]
- Wang, Z.; Jiang, Y.; Yang, X.; Zhao, J.; Fu, W.; Wang, N.; Wang, D.-Y. Surface Modification of Ammonium Polyphosphate for Enhancing Flame-Retardant Properties of Thermoplastic Polyurethane. Materials 2022, 15, 1990. [Google Scholar] [CrossRef] [PubMed]
- Tan, Y.; Shao, Z.-B.; Chen, X.-F.; Long, J.-W.; Chen, L.; Wang, Y.-Z. Novel Multifunctional Organic–Inorganic Hybrid Curing Agent with High Flame-Retardant Efficiency for Epoxy Resin. ACS Appl. Mater. 2015, 7, 17919–17928. [Google Scholar] [CrossRef] [PubMed]
- Yan, J.; Xu, P.; Zhang, P.; Fan, H. Surface-modified ammonium polyphosphate for flame-retardant and reinforced polyurethane composites. Colloid. Surface A 2021, 626, 127092. [Google Scholar] [CrossRef]
- Waaijers, S.L.; Kong, D.; Hendriks, H.S.; de Wit, C.A.; Cousins, I.T.; Westerink, R.H.S.; Leonards, P.E.G.; Kraak, M.H.S.; Admiraal, W.; de Voogt, P.; et al. Persistence, Bioaccumulation, and Toxicity of Halogen-Free Flame Retardants. Rev. Environ. Contam. T. 2013, 222, 1–71. [Google Scholar]
- Paerl, H.W.; Otten, T.G. Harmful Cyanobacterial Blooms: Causes, Consequences, and Controls. Microb. Ecol. 2013, 65, 995–1010. [Google Scholar] [CrossRef] [PubMed]
- Ahlgren, J.; De Brabandere, H.; Reitzel, K.; Rydin, E.; Gogoll, A.; Waldebäck, M. Sediment Phosphorus Extractants for Phosphorus-31 Nuclear Magnetic Resonance Analysis. J. Environ. Qual. 2007, 36, 892–898. [Google Scholar] [CrossRef]
- Hupfer, M.; Glöss, S.; Schmieder, P.; Grossart, H.-P. Methods for Detection and Quantification of Polyphosphate and Polyphosphate Accumulating Microorganisms in Aquatic Sediments. Int. Rev. Hydrobiol. 2008, 93, 1–30. [Google Scholar] [CrossRef]
- Iammarino, M.; Taranto, A. Determination of polyphosphates in products of animal origin: Application of a validated ion chromatography method for commercial samples analyses. Eur. Food Res. Technol. 2012, 235, 409–417. [Google Scholar] [CrossRef]
- Lee, A.; Whitesides, G.M. Analysis of inorganic polyphosphates by capillary gel electrophoresis. Anal. Chem. 2010, 82, 6838–6846. [Google Scholar] [CrossRef] [PubMed]
- Wang, L.; Li, J.; Zhang, L. Determination of polyphosphates in fish and shrimp muscles by capillary electrophoresis with indirect UV detection after phosphatase inhibition using high pressure pretreatment. Food Chem. 2015, 185, 349–354. [Google Scholar] [CrossRef] [PubMed]
- Diaz, J.M.; Ingall, E.D. Fluorometric Quantification of Natural Inorganic Polyphosphate. Environ. Sci. Technol. 2010, 44, 4665–4671. [Google Scholar] [CrossRef] [PubMed]
- Jin, X.; Sun, T.; Wu, Z.; Wang, D.; Hu, F.; Xu, J.; Li, X.; Qiu, J. Label-free hairpin probe for the rapid detection of Hg(II) based on T-Hg(II)-T. Anal. Chim. Acta 2022, 1221, 340113. [Google Scholar] [CrossRef] [PubMed]
- Beccia, M.R.; Biver, T.; Pardini, A.; Spinelli, J.; Secco, F.; Venturini, M.; Busto, N.; Lopez-Cornejo, P.; Martin Herrera, V.I.; Prado-Gotor, R. The fluorophore 4′,6-diamidino-2-phenylindole (DAPI) induces DNA folding in long double-stranded DNA. Chem. Asian J. 2012, 7, 1803–1810. [Google Scholar] [CrossRef] [PubMed]
- Gunther, S.; Trutnau, M.; Kleinsteuber, S.; Hause, G.; Bley, T.; Roske, I.; Harms, H.; Muller, S. Dynamics of Polyphosphate-Accumulating Bacteria in Wastewater Treatment Plant Microbial Communities Detected via DAPI (4′,6′-Diamidino-2-Phenylindole) and Tetracycline Labeling. Appl. Environ. Microbiol. 2009, 75, 2111–2121. [Google Scholar] [CrossRef] [PubMed]
- Fei, X.; Li, W.; Wang, C.; Jiao, X.; Zhang, X. Simulation and experimental study of fluorescence labeled polyphosphate in microthrix parvicella. J. Mol. Graph. Model. 2021, 104, 107842. [Google Scholar] [CrossRef]
- Christ, J.J.; Willbold, S.; Blank, L.M. Methods for the Analysis of Polyphosphate in the Life Sciences. Anal. Chem. 2020, 92, 4167–4176. [Google Scholar] [CrossRef]
- Shanableh, A.M.; Elsergany, M.M. Removal of phosphate from water using six Al-, Fe-, and Al-Fe-modified bentonite adsorbents. J. Environ. 2013, 48, 223–231. [Google Scholar] [CrossRef]
- Joseph, S.; Kammann, C.I.; Shepherd, J.G.; Conte, P.; Schmidt, H.-P.; Hagemann, N.; Rich, A.M.; Marjo, C.E.; Allen, J.; Munroe, P.; et al. Microstructural and associated chemical changes during the composting of a high temperature biochar: Mechanisms for nitrate, phosphate and other nutrient retention and release. Sci. Total Environ. 2018, 618, 1210–1223. [Google Scholar] [CrossRef] [PubMed]
- Usman, M.O.; Aturagaba, G.; Ntale, M.; Nyakairu, G.W. A review of adsorption techniques for removal of phosphates from wastewater. Water Sci. Technol. 2022, 86, 3113–3132. [Google Scholar] [CrossRef]
- Clark, T.; Stephenson, T.; Pearce, P.A. Phosphorus removal by chemical precipitation in a biological aerated filter. Water Res. 1997, 31, 2557–2563. [Google Scholar] [CrossRef]
- Sun, W.; Ma, G.; Sun, Y.; Liu, Y.; Song, N.; Xu, Y.; Zheng, H. Effective treatment of high phosphorus pharmaceutical wastewater by chemical precipitation. Can. J. Chem. Eng. 2017, 95, 1585–1593. [Google Scholar] [CrossRef]
- Li, H.; Zhong, Y.; Huang, H.; Tan, Z.; Sun, Y.; Liu, H. Simultaneous nitrogen and phosphorus removal by interactions between phosphate accumulating organisms (PAOs) and denitrifying phosphate accumulating organisms (DPAOs) in a sequencing batch reactor. Sci. Total Environ. 2020, 744, 140852. [Google Scholar] [CrossRef]
- Lu, X.; Duan, H.; Oehmen, A.; Carvalho, G.; Yuan, Z.; Ye, L. Achieving combined biological short-cut nitrogen and phosphorus removal in a one sludge system with side-stream sludge treatment. Water Res. 2021, 203, 117563. [Google Scholar] [CrossRef]
- Cunningham, J.E.; Kuiack, C. Production of citric and oxalic acids and solubilization of calcium phosphate by Penicillium bilaii. Appl. Environ. Microbiol. 1992, 58, 1451–1458. [Google Scholar] [CrossRef]
- Oehmen, A.; Zeng, R.J.; Yuan, Z.; Keller, J. Anaerobic metabolism of propionate by polyphosphate-accumulating organisms in enhanced biological phosphorus removal systems. Biotechnol. Bioeng. 2005, 91, 43–53. [Google Scholar] [CrossRef] [PubMed]
- Bergogne-Bérézin, E.; Towner, K.J. Acinetobacter spp. as nosocomial pathogens: Microbiological, clinical, and epidemiological features. Clin. Microbiol. Rev. 1996, 9, 148–165. [Google Scholar] [CrossRef]
- Yan, L.; Yan, N.; Gao, X.-Y.; Liu, Y.; Liu, Z.-P. Degradation of amoxicillin by newly isolated Bosea sp. Ads-6. Sci. Total Environ. 2022, 828, 154411. [Google Scholar] [CrossRef]
- Ying, J.-J.; Fang, Y.-C.; Ye, Y.-L.; Wu, Z.-C.; Xu, L.; Han, B.-N.; Sun, C. Marinomonas vulgaris sp. nov., a marine bacterium isolated from seawater in a coastal intertidal zone of Zhoushan island. Arch. Microbiol. 2021, 203, 5133–5139. [Google Scholar] [CrossRef] [PubMed]
- He, S.; McMahon, K.D. Microbiology of ‘Candidatus Accumulibacter’ in activated sludge. Microb. Biotechnol. 2011, 4, 603–619. [Google Scholar] [CrossRef] [PubMed]
- Carr, E.; Kämpfer, P.; Patel, B.; Gűrtler, V.; Seviour, R. Seven novel species of Acinetobacter isolated from activated sludge. Int. J. Syst. Evol. Microbiol. 2003, 53, 953–963. [Google Scholar] [CrossRef] [PubMed]
- Ogut, M.; Er, F.; Kandemir, N. Phosphate solubilization potentials of soil Acinetobacter strains. Biol. Fertil. 2010, 46, 707–715. [Google Scholar] [CrossRef]
- Han, Y.-H.; Fu, T.; Wang, S.-S.; Yu, H.-T.; Xiang, P.; Zhang, W.-X.; Chen, D.-L.; Li, M.J.B. Efficient phosphate accumulation in the newly isolated Acinetobacter junii strain LH4. 3 Biotech 2018, 8, 313. [Google Scholar] [CrossRef]
- Lal, B.; Vijayakumar, S.; Anandan, S.; Veeraraghavan, B. Specimen Collection, Processing, Culture, and Biochemical Identification of Acinetobacter spp. Methods Mol. Biol. 2019, 1946, 1–15. [Google Scholar]

Disclaimer/Publisher’s Note: The statements, opinions and data contained in all publications are solely those of the individual author(s) and contributor(s) and not of MDPI and/or the editor(s). MDPI and/or the editor(s) disclaim responsibility for any injury to people or property resulting from any ideas, methods, instructions or products referred to in the content. |
© 2024 by the authors. Licensee MDPI, Basel, Switzerland. This article is an open access article distributed under the terms and conditions of the Creative Commons Attribution (CC BY) license (https://creativecommons.org/licenses/by/4.0/).
Share and Cite
Li, X.; Cai, Y.; Qiu, Q.; Wu, J.; Wang, J.; Qiu, J. Monitoring Ammonium Polyphosphate (APP) Biodegradation by Acinetobacter nosocomialis D-3 Using DAPI. Molecules 2024, 29, 2667. https://doi.org/10.3390/molecules29112667
Li X, Cai Y, Qiu Q, Wu J, Wang J, Qiu J. Monitoring Ammonium Polyphosphate (APP) Biodegradation by Acinetobacter nosocomialis D-3 Using DAPI. Molecules. 2024; 29(11):2667. https://doi.org/10.3390/molecules29112667
Chicago/Turabian StyleLi, Xiangxiang, Yule Cai, Qiqing Qiu, Jiamin Wu, Jing Wang, and Jieqiong Qiu. 2024. "Monitoring Ammonium Polyphosphate (APP) Biodegradation by Acinetobacter nosocomialis D-3 Using DAPI" Molecules 29, no. 11: 2667. https://doi.org/10.3390/molecules29112667
APA StyleLi, X., Cai, Y., Qiu, Q., Wu, J., Wang, J., & Qiu, J. (2024). Monitoring Ammonium Polyphosphate (APP) Biodegradation by Acinetobacter nosocomialis D-3 Using DAPI. Molecules, 29(11), 2667. https://doi.org/10.3390/molecules29112667





